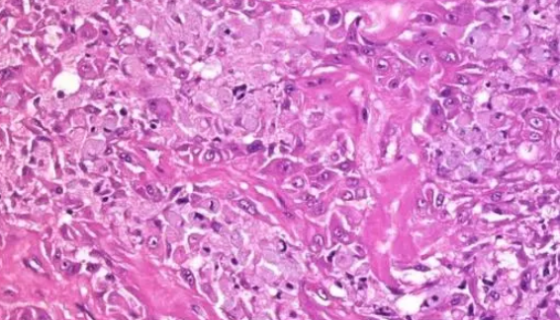
LTEP-S人肺鳞癌细胞收到后的处理方法与培养步骤！

大肠埃希氏菌的健康危害与检验标准及限量要求!
大肠埃希氏菌简称大肠杆菌,系人和温血动物后肠段正常菌丛的主要...

人血管平滑肌细胞的培养步骤与注意事项!
T/G HA-VSMC(人血管平滑肌细胞)的运输和保存与培养...

ATCC 29213金黄色葡萄球菌金黄亚种的注意事项!
金黄色葡萄球菌金黄亚种是Staphylococcus属的微生...

肺炎链球菌的培养特性与生化反应及鉴别要点!
肺炎链球菌现属于链球菌科的链球菌属。革兰染色阳性,菌体呈矛头...
LTEP-S人肺鳞癌细胞收到后的处理方法与培养步骤!
人肺鳞癌细胞收到后的处理方法与培养步骤及注意事项有哪些?

芽孢杆菌在工农业及医药生产中的广泛应用!
芽孢杆菌(Bacillus),细菌的一科,能形成芽孢(内生孢...

H9C2大鼠心肌细胞的培养步骤与应用!
H9C2大鼠心肌细胞是原始克隆细胞系的亚克隆,该细胞系由Ki...

ATCC 33478 远缘链球菌 百欧博伟生物
ATCC 33478 远缘链球菌知识解析,本菌仅用于科学研究...

ATCC 19404 生孢梭菌冻干管打管说明书!
生孢梭菌(Clostridium sporogenes)又译...